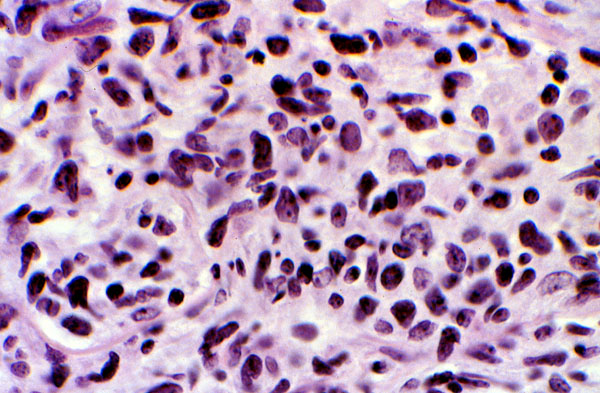

Low grade follicular lymphoma, histology
Click picture to enlarge. Close window to return
This high power view of a follicular lymphoma shows the neoplastic cells to be predominantly small in size, with nuclei showing folds and clefts (cleaved cells). Note: These cells do not have nucleoli, and mitoses are few.